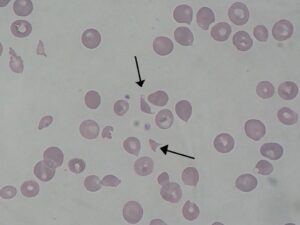
용혈성 요독증후군 파편적 혈구 현미경 사진

용혈성 요독 증후군(HUS)에서 관찰되는 파편적혈구
By Paulo Henrique Orlandi Mourao – Own work, CC BY-SA 3.0, wikimedia commons.
‘햄버거병’이라는 표현은 공식 의학 용어가 아니다. 질병관리 체계나 국제 질병 분류 어디에도 이 명칭은 등장하지 않는다. 한국에서 이 말이 실제로 가리켜 온 대상은 장출혈성 대장균 감염(EHEC infection) 전반이 아니라, 그 감염이 진행된 끝에 나타나는 용혈성 요독 증후군(HUS)다.
사회적 통칭의 부재
장출혈성 대장균 감염 자체는 오래전부터 알려져 왔다. 국내에서도 해당 감염 사례는 지속적으로 보고돼 왔지만, 그 시기에는 대부분 전문 용어로만 다뤄졌고 대중적으로 통용되는 별칭은 없었다. 다시 말해, 질병은 존재했지만 사회적으로 각인된 이름은 아직 없던 상태였다.
1982년 미국 사례
1982년, 미국 오리건주와 미시간주에서 덜 익은 햄버거 패티를 먹은 사람들 사이에서 용혈성 요독 증후군이 집단으로 발생하는 사건이 보고됐다. 이 사건을 계기로 의학계는 해당 중증 증후군의 원인이 장출혈성 대장균 O157:H7 감염이라는 사실을 처음으로 규명하게 된다.
이후 이 질환은 언론과 대중 담론 속에서 ‘햄버거를 먹고 걸린 병’이라는 설명과 함께 언급되기 시작했고, 시간이 흐르며 햄버거병(Hamburger disease)이라는 별칭으로 굳어졌다.
2016년, 언론을 통한 확산

이미지 출처: 픽사베이
한국에서는 2016년, ‘햄버거병’이라는 표현이 언론 보도 속에서 본격적으로 자리 잡기 시작한다. 맥도날드의 햄버거를 먹은 어린이가 장출혈성 대장균 감염 진단을 받았다는 주장이 제기되며 소송으로까지 이어졌고, 이 과정은 장기간에 걸쳐 언론에 보도됐다.
당시 언론은 복잡한 의학 용어보다 독자가 즉각적으로 이해할 수 있는 표현을 선택했다. 그 결과 ‘햄버거병’이라는 말이 기사 제목과 본문에서 반복적으로 등장하기 시작했다.
중요한 점은 이 표현이 처음부터 병명을 대신하기 위해 만들어진 것이 아니라 사건을 설명하기 위한 언어로 사용되기 시작했다는 점이다.
남는 문제 하나
이 명칭은 위험성을 빠르게 전달하는 데에는 효과적이지만, 동시에 오해를 낳을 소지가 크다. 장출혈성 대장균 감염은 햄버거에만 국한된 문제가 아니기 때문이다. 그럼에도 불구하고 이 표현이 살아남은 이유는 감염 그 자체보다 용혈성 요독 증후군이라는 최악의 결과를 직관적으로 떠올리게 하기 때문이다.